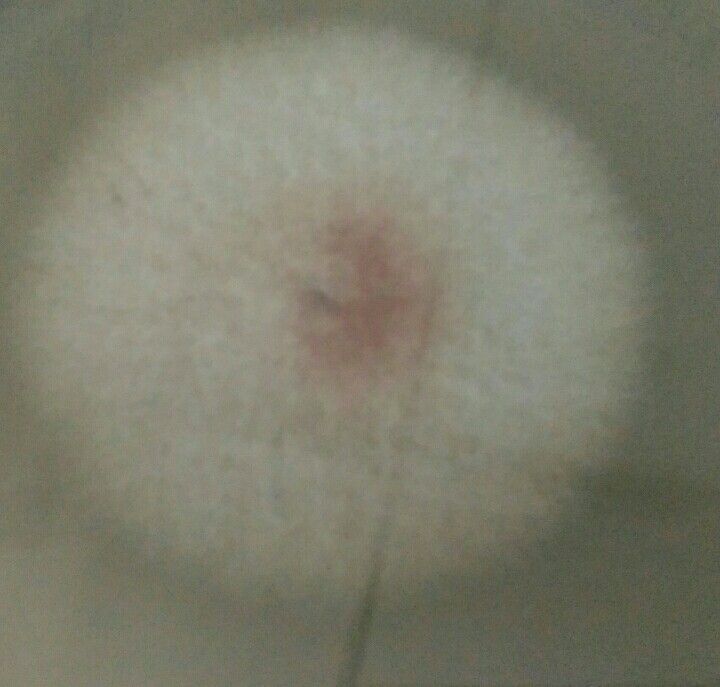

A plant pathogen- Fusarium
 Jan 01, 2019 • 11:15 PM UTC
Jan 01, 2019 • 11:15 PM UTC Unknown Location
Unknown Location 140x Magnification
140x Magnification Unknown
Unknown
Madhavi Kanade
Learn about the author...
14posts
4comments
1locations

View in Media Gallery
Fusarium oxysporum an ascomycete fungus which comprises all the species, varieties. It is major wilt pathogen of many economically important crop plants. This fungal pathogen affects a wide variety of hosts plants of any age. It generally produces symptoms such as wilting, chlorosis, necrosis, premature leaf drop etc. The known culture of Fusarium were collected from ICAR Goa & Agharkar research institute, Pune. Spores of this culture seen under foldscope.
View in Media Gallery
Fusarium (from ICAR -Goa) growth on PDA

View in Media Gallery
Spores of Fusarium (ICAR -Goa) under foldscope

View in Media Gallery
Spores of Fusarium (ICAR -Goa) under foldscope

View in Media Gallery
Fusarium spores (from ICAR -Goa) stained by methyl red,under foldscope

View in Media Gallery
Fusarium (ICAR -Goa) stain by methyl red

View in Media Gallery
Fusarium spores (ICAR -Goa) stain by methyl red

View in Media Gallery
Fusarium (ARI, Pune) growth on PDA

View in Media Gallery
Fusarium (ARI, Pune) spores stain by methyl red, under foldscope

View in Media Gallery
Fusarium (ARI, Pune) spores stain by methyl red under foldscope

View in Media Gallery
Fusarium (ARI , Pune ) spores stain by methyl red under foldscope
Sign in to commentNobody has commented yet... Share your thoughts with the author and start the discussion!

 0 Applause
0 Applause 0 Comments
0 Comments










